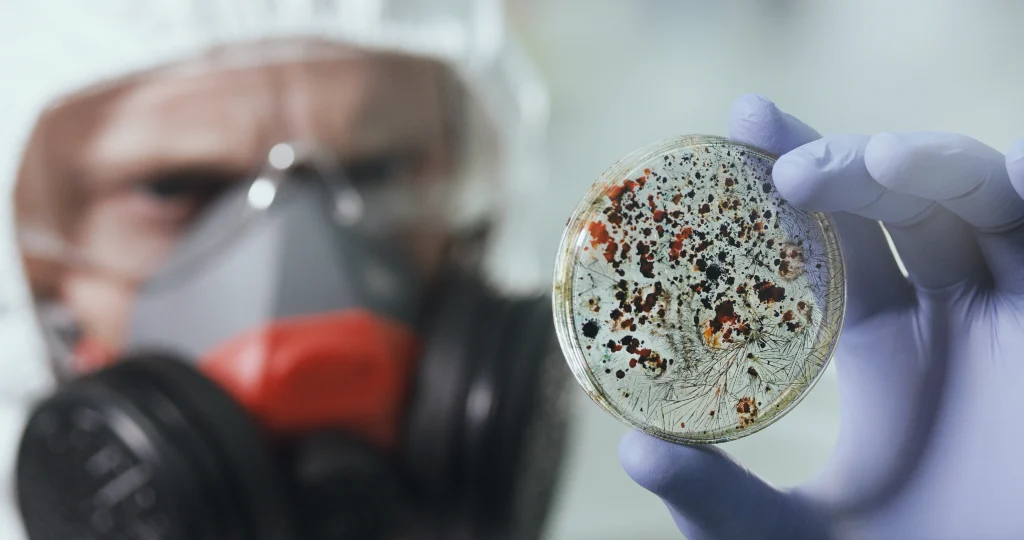
Laboratory technician holding a petri dish with visible microbial growth, illustrating contamination pathways caused by degraded or porous coatings.

The floors of your facility may have floor coating contamination risks today—installed years ago without any visible signs of failure.
Most facilities monitor coatings for cracks, chips, or delamination. But coating contamination risks often develop at a microscopic or chemical level long before surface damage appears. These hidden risks can affect product quality, trigger compliance issues, and increase operational exposure across food processing, packaging, and regulated manufacturing environments.
Industrial coating contamination risks extend beyond visible degradation. They include chemical off-gassing, microbial harboring, incompatibility with sanitation protocols, chemical migration, and material breakdown under real operating conditions. Standard visual inspections rarely detect these issues until contamination events have already occurred.
Below are five contamination risks commonly overlooked in legacy coating systems—and why material selection is critical for prevention.
1. Chemical Off-Gassing From Legacy Floor Coatings

Many traditional coating systems continue to release residual volatile compounds long after curing. Temperature fluctuations, mechanical stress, and natural aging can accelerate this off-gassing over the coating’s service life.
In contamination-sensitive environments, this is not just an air-quality concern. Off-gassing can affect enclosed production areas, packaging zones, and temperature-controlled spaces where products remain exposed for extended periods. Elevated temperatures—such as those created during steam cleaning or thermal processing—can further increase release rates, creating persistent low-level exposure that ventilation alone cannot fully mitigate.
2. Surface Porosity and Microbial Harboring

The microscopic surface structure of a coating determines whether it resists or harbors contamination. Many conventional coatings cure with surface porosity that creates microscopic voids where moisture, organic material, and microorganisms can accumulate beyond the reach of routine cleaning.
Over time, these surfaces can become reservoirs for microbial growth—even when sanitation protocols are properly followed. In regulated environments, repeated environmental monitoring failures are often traced back to intact-appearing coatings that harbor contamination at a microscopic level.
Addressing this risk requires coatings engineered with non-porous surface chemistry, not simply more aggressive cleaning.
3. Incompatibility With Sanitation and Cleaning Protocols

Aggressive sanitation protocols are essential for contamination control, but they can unintentionally accelerate coating degradation when materials lack chemical resistance.
Quaternary ammonium compounds, chlorine-based cleaners, caustics, and acidic agents gradually attack vulnerable coating chemistries. As degradation progresses, surface roughness and porosity increase—transforming the coating from a protective barrier into a contamination source.
Because early degradation is invisible, facilities often develop false confidence in coatings that appear intact while contamination risk quietly increases. Facilities operating under strict sanitation requirements must ensure their coating systems are designed to withstand repeated exposure to required cleaning agents.
4. VOC Migration and Cross-Contamination
Beyond airborne release, some coating systems create contamination pathways through direct chemical migration.
When coated surfaces come into contact with packaging materials, conveyors, or equipment, chemical constituents can transfer across interfaces—particularly under heat, pressure, or prolonged contact. This risk increases in facilities handling paper, cardboard, or porous plastics, where migration potential is higher.
Temperature cycling further accelerates this process, increasing surface permeability over time. Coatings intended to protect infrastructure can inadvertently affect downstream product quality if migration risks are not addressed at the material level.
5. Material Breakdown Under Industrial Operating Conditions

Industrial environments expose coatings to mechanical wear, chemical stress, moisture, and thermal cycling—all of which accelerate material breakdown.
As coatings degrade, they can release particulates or leach chemical constituents into cleaning water, condensate, or runoff systems. Particulate contamination is especially problematic in regulated manufacturing and food environments, where foreign material detection can trigger investigations, production holds, and product disposal.
Because degradation occurs gradually, contamination risk often emerges long before visible coating failure prompts corrective action.
Why Timing Matters: Recognition of Floor Coating Contamination Risks Comes Too Late

The central challenge with coating contamination risks is timing.
Microscopic changes in surface chemistry and material integrity occur long before visible failure. Facilities relying solely on visual inspection often miss the window where proactive intervention could prevent contamination events.
By the time coating failure becomes obvious, product impact has often already occurred—along with the associated downtime, investigations, and compliance risk.
Application Considerations Across Industrial Environments
Food Processing Facilities
Food processing environments face the most stringent contamination control requirements. Coatings must maintain non-porous, cleanable surfaces while withstanding aggressive sanitation protocols throughout their service life. Any coating chemistry that degrades under mandated cleaning introduces unacceptable contamination risk.
Packaging Operations
Packaging facilities face indirect contamination risks through airborne particulates, surface contact with packaging materials, and personnel transfer. Coatings must resist mechanical wear while minimizing off-gassing and migration risks—especially for moisture-sensitive or long shelf-life products.
Manufacturing Environments
Facilities producing components for regulated industries must control particulate contamination from all facility surfaces. Coating selection must align with cleanliness classifications and the contamination sensitivity of production processes, not just durability requirements.
Commercial and Institutional Facilities
Healthcare, education, and food service environments require coatings that maintain hygiene performance across diverse cleaning protocols and long service lives. Contamination risk assessment must consider lifecycle degradation—not just initial performance.
BioBond Plant-Based Protective Coatings: A Materials-Based Solution

BioBond protective coatings are engineered to eliminate the contamination pathways common in many conventional systems.
Plant-based formulations cure into non-porous surfaces that resist microbial harboring, chemical migration, and degradation under aggressive cleaning protocols. Low VOC formulations reduce off-gassing risk, while no added microplastics help minimize particulate contamination in sensitive environments.
Third-party certifications—including USDA BioPreferred and Intertek Clean Air GOLD—provide independent validation that supports contamination control programs and regulatory documentation.
A Better Framework for Preventing Floor Coating Contamination Risks
Protective coatings should be evaluated with the same rigor applied to equipment, raw materials, and processes.
When properly engineered, coatings function as contamination barriers. When overlooked, they become contamination sources. Shifting from reactive remediation to materials-based prevention allows facilities to reduce risk, simplify compliance, and protect long-term operational performance.
Technical Consultation and Materials Evaluation
Evaluate your facility’s protective coating system for contamination control performance.
BioBond technical specialists provide materials assessments tailored to your operational requirements and contamination sensitivity.
Protective Coatings: CoatingsInfo@biobondadhesives.com
Adhesives: AdhesivesInfo@biobondadhesives.com
General Inquiries: info@biobondadhesives.com
Or visit our Contact page.
BioBond: Better Price. Better Performance. Better for Everyone.





